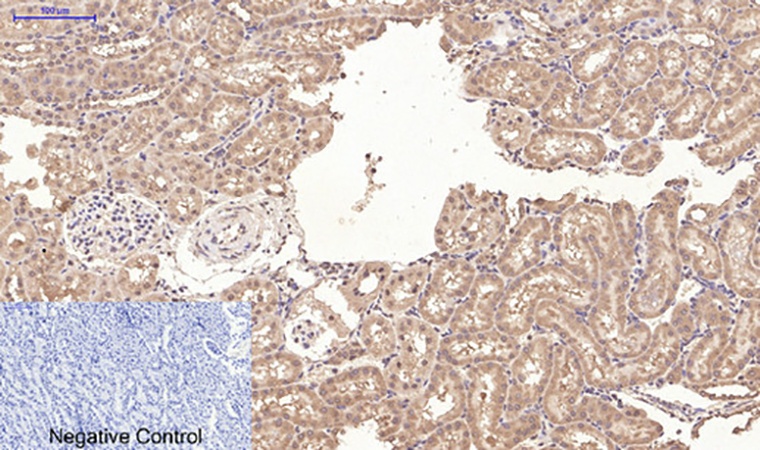
Fig.5. Immunohistochemical analysis of paraffin-embedded rat kidney tissue. 1, CD10 Monoclonal Antibody was diluted at 1:200 (4°C, overnight). 2, Sodium citrate pH 6.0 was used for antibody retrieval (>98°C, 20min). 3, secondary antibody was diluted at 1:200 (room temperature, 30min). Negative control was used by secondary antibody only.

| Product name | CD10 Monoclonal Antibody |
| Immunogen | Synthetic Peptide |
| Host | Mouse |
| Reactivity | Human,Mouse,Rat |
| Applications | IF,IHC |
| Applications notes | Optimal working dilutions should be determined experimentally by the investigator. Suggested starting dilutions are as follows: IF 1:50-200;IHC 1:50-200 |
| Clonality | Monoclonal |
| Preparation method | The antibody was affinity-purified from mouse ascites by affinity-chromatography using specific immunogen. |
| Alternative | MME; EPN; Neprilysin; Atriopeptidase; Common acute lymphocytic leukemia antigen; CALLA; Enkephalinase; Neutral endopeptidase 24.11; NEP; Neutral endopeptidase; Skin fibroblast elastase; SFE; CD10 |
| Formulation | Liquid solution |
| Concentration | 1 mg/ml |
| Storage buffer | PBS, pH 7.4, containing 0.5%BSA, 0.02% sodium azide as Preservative and 50% Glycerol. |
| Storage instructions | Stable for one year at -20°C from date of shipment. For maximum recovery of product, centrifuge the original vial after thawing and prior to removing the cap. Aliquot to avoid repeated freezing and thawing. |
| Shipping | Gel pack with blue ice. |
| Precautions | The product listed herein is for research use only and is not intended for use in human or clinical diagnosis. Suggested applications of our products are not recommendations to use our products in violation of any patent or as a license. We cannot be responsible for patent infringements or other violations that may occur with the use of this product. |
| Background | MME encodes a common acute lymphocytic leukemia antigen that is an important cell surface marker in the diagnosis of human acute lymphocytic leukemia (ALL). Membrane metalloendopeptidase is present on leukemic cells of pre-B phenotype, which represent 85% of cases of ALL. Membrane metalloendopeptidase is not restricted to leukemic cells, however, and is found on a variety of normal tissues. It is a glycoprotein that is particularly abundant in kidney, where it is present on the brush border of proximal tubules and on glomerular epithelium. Membrane metalloendopeptidase is a neutral endopeptidase that cleaves peptides at the amino side of hydrophobic residues and inactivates several peptide hormones including glucagon, enkephalins, substance P, neurotensin, oxytocin, and bradykinin. This gene, which encodes a 100-kD type II transmembrane glycoprotein, exists in a single copy of greater than 45 kb. The 5' untranslated region of MME is alternatively spliced, resulting in four separate mRNA transcripts. The coding region is not affected by alternative splicing. |
| Gene ID | 4311 |
| Alternative | MME; EPN; Neprilysin; Atriopeptidase; Common acute lymphocytic leukemia antigen; CALLA; Enkephalinase; Neutral endopeptidase 24.11; NEP; Neutral endopeptidase; Skin fibroblast elastase; SFE; CD10 |
| Others | The antibody detects endogenous CD10 proteins. |
| Accession | P08473 |

Fig.1. Immunofluorescence analysis of human uterus tissue. 1, CD10 Monoclonal Antibody (red) was diluted at 1:200 (4°C, overnight). 2, Cy3 Labeled secondary antibody was diluted at 1:300 (room temperature, 50min). 3, Picture B: DAPI (blue) 10min. Picture A: Target. Picture B: DAPI. Picture C: merge of A+B.

Fig.2. Immunofluorescence analysis of rat kidney tissue. 1, CD10 Monoclonal Antibody (red) was diluted at 1:200 (4°C, overnight). 2, Cy3 Labeled secondary antibody was diluted at 1:300 (room temperature, 50min). 3, Picture B: DAPI (blue) 10min. Picture A: Target. Picture B: DAPI. Picture C: merge of A+B.

Fig.3. Immunohistochemical analysis of paraffin-embedded human uterus tissue. 1, CD10 Monoclonal Antibody was diluted at 1:200 (4°C, overnight). 2, Sodium citrate pH 6.0 was used for antibody retrieval (>98°C, 20min). 3, secondary antibody was diluted at 1:200 (room temperature, 30min). Negative control was used by secondary antibody only.

Fig.4. Immunohistochemical analysis of paraffin-embedded mouse lung tissue. 1, CD10 Monoclonal Antibody was diluted at 1:200 (4°C, overnight). 2, Sodium citrate pH 6.0 was used for antibody retrieval (>98°C, 20min). 3, secondary antibody was diluted at 1:200 (room temperature, 30min). Negative control was used by secondary antibody only.
Fig.5. Immunohistochemical analysis of paraffin-embedded rat kidney tissue. 1, CD10 Monoclonal Antibody was diluted at 1:200 (4°C, overnight). 2, Sodium citrate pH 6.0 was used for antibody retrieval (>98°C, 20min). 3, secondary antibody was diluted at 1:200 (room temperature, 30min). Negative control was used by secondary antibody only.
You must be logged in to post a review.
Reviews
There are no reviews yet.